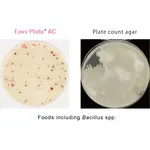
Easy Plate Prepared Media Plates

Easy Plate Prepared Media Plates
Make microbiological testing of food easier
Save time and budget by making the switch to Easy Plate Prepared Media Plates, the convenient solution for faster and easier microbiological testing. Using a time-tested and AOAC validated culture media methodology, Easy Plate comes in a ready-to-use, space saving stackable film plate format that reduces waste, eliminates preparation time, and streamlines your test procedures. Each Easy Plate is specialized for a specific target organism or organism group with options for Aerobic Bacteria (AC), Coliforms (CC), E. coli/Coliforms (EC), Staphylococcus aureus (SA) and Yeast and Mold (YM-R).
Save Time & Space
- No need for messy media preparation or sterilization.
- Faster sample inoculation without special equipment.
- Slim profile & stackable design makes Easy Plate easy to store and incubate.
Simple Operation, Reliable Results
- Test results correlate well with conventional plate method testing.
- Easy to operate with minimal training.
- AOAC Research Institute (AOACRI) Performance Test Methods (PTM) and MicroVal Certified.
Reduces Waste and Incubation Space
- Increase your incubation volume - Easy plates take up 1/20th of the space needed by a petri dish.
- Greenhouse gas emissions reduced compared to traditional agar plates.

Available Options:
Aerobic Bacteria (Easy Plate AC)
AOAC PTM certified custom media formulation for cultivation of aerobic bacteria. Microbial test kit contains a chemical redox indicator that provides easily distinguishable colored red colonies, allowing you to easily identify and count aerobic bacteria in 48 ± 2 hours. Easy Plate AC is AOAC PTM certified and sold in packages of 100 tests in 4 separate bags containing 25 tests each. The shelf life of 18 months when stored unopened at 2-8℃.
Click Here for Easy Plate AC Instructions
Rapid Type Aerobic Bacteria (Easy Plate AC-R)
A custom media formulation for cultivation of aerobic bacteria. The prepared plate contains a chemical indicator that provides easily distinguishable red-colored colonies, allowing users to easily identify and count aerobic bacteria in 24±1 hours. Sold in packages of 100 tests in 4 separate bags containing 25 tests each.The shelf life of 12 months when stored unopened at 2-8℃.
Click Here for Easy Plate AC Instructions
Coliform (Easy Plate CC)
AOAC PTM certified custom media formulation for detection, identification, and enumeration of coliforms. Microbial test kit includes a chromogenic substrate that causes coliforms to exhibit a distinguishable blue color allowing you to easily identify and quantify coliforms in 24 ± 1 hours. This distinct coloring of the colonies also helps to overcome common interferences in food testing for coliforms and makes counting easier. Easy Plate CC is AOAC PTM certified and sold in packages of 100 tests in 4 separate bags containing 25 tests each. The shelf life of 18 months when stored unopened at 2-8℃.
Click Here for Easy Plate CC Instructions
E. coli / Coliform (Easy Plate EC)
AOAC PTM certified custom media formulation for detection, identification and enumeration of E. coli and non-E. coli coliforms. A microbial test kit that includes two chromogenic substrates that cause E. coli to exhibit a blue-purple to navy blue color while non-E. coli coliforms exhibit pink to red-purple color allowing you to distinguish each in your analysis* in approximately 24 hours. The distinct coloring of the colonies helps to overcome common interferences in food and water testing to make testing and enumeration of E. coli and coliforms easier. Easy Plate EC is AOAC PTM certified and sold in packages of 100 tests in 4 separate bags containing 25 tests each. The shelf life of 18 months when stored unopened at 2-8℃.
Click Here for Easy Plate EC Instructions
* While most E. coli produce β-glucuronidase, E. coli O157 does not specifically produce β-glucuronidase, and it therefore exhibits a red-purple similar to that of non-E. coli coliforms. This needs to be considered in your analysis and conclusions.
* In some unheated foods and dairy products, residual enzymes in the food may cause a red-violet coloring to develop over the entire incubation area. If the visibility of the colonies is affected, improvement can be obtained using dilutions.
Staphylococcus aureus (Easy Plate SA)
AOAC PTM certified custom media formulation for cultivation of Staphylococcus aureus. A microbial test kit that contains a chromogenic substrate that produces easily distinguishable brightly colored blue colonies, allowing you to easily identify and quantify Staphylococcus aureus. Compared to Baired-Parker agar and Mannitol salt agar with egg yolk which takes 48 hours, Easy Plate SA incubation time is reduced to in 24 ± 1 hours. Easy Plate SA also contain inhibitors reducing the growth of non-Staphylococcus aureus, but if they grow, the colonies will exhibit a pink to red-violet color making them easy to distinguish. Easy Plate SA is AOAC PTM certified and sold in packages of 100 tests in 4 separate bags containing 25 tests each. The shelf life of 12 months when stored unopened at 2-8℃.
Click Here for Easy Plate SA Instructions
Yeast and Mold (Easy Plate YM-R)
A rapid-type prepared media plates for yeast and mold. Colonies are clearly colored in 48 ± 2 hours. This microbial test kit has a shorter incubation time than agar media. The redox indicator creates purple colonies, making it easy to identify and count colonies even in the presence of food residues. The mold colonies spread widely and form purple colonies with diffuse edges. Yeast colonies form small circles and with defined edges.
Click Here for Easy Plate YM-R Instructions
Enterobacteriaceae (Easy Plate EB)
Easy Plate EB is intended to indicate the level of Enterobacteriaceae bacteria in food and beverage products. Colonies are clearly colored in 48 ± 1 hours. All red colonies should be counted, regardless of size. If the growth area is entirely orange and red spots cannot be seen, it is considered negative. Easy Plate EB is manufactured in an ISO 9001 certified site.
Click Here for Easy Plate EB Instructions
Free Software for Automated Colony Analysis Available

Boost productivity with the automated Colony Counting System for Easy Plate. This free software program is easier and more efficient than manual colony counting. Simply scan up to 7 Easy Plates at a time using the Brothers Industries Printer Model ADS-4300N (Available as item 5300-55) and the images will be imported into the Colony Counting System for Easy Plate software for analysis.
Click Here to Request the Free Colony Counting Software
![]()
Products ship on ice in a foam box. Shipments cannot be over weekends.